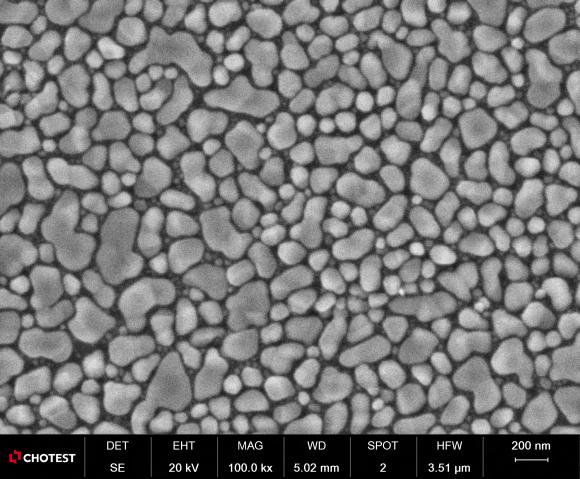
在这里插入图片描述

扫描电镜(SEM)作为现代微观形貌分析的“眼睛”,其价值已渗透到材料科学、生命科学、工业检测等多个领域。然而,面对不同品牌、型号和配置的SEM,许多用户在设备选型时常感到困惑。要制定有效的SEM使用攻略,需跳出参数堆砌,从技术本质与应用场景出发。
1、首先明确你的测量需求,精准定义自己观测目标。
要知道不同样本对电镜的要求天差地别。比如你要观测如细胞组织等生物样本,通常需低真空模式和冷冻传输系统防止脱水变形;而如果你需要分析金属断口,则要求高真空模式和背散射电子探测器才能凸显成分对比。
2、注意区分不同的SEM的差异。
如生物领域常用低真空的SEM来观察未喷金的活细胞或含水样品,因为低真空环境能抑制样品脱水。
而在工业场景中,常用高分辨率+大景深的SEM对样品进行微观尺度形貌观测和分析,如在金属材料分析中的应用:
(1)磁性材料分析(铷铁硼)
CEM3000A台式扫描电镜高分辨背散射图片可清晰观察到“冰糖块状”的Nd2Fe14B晶粒结构,以及富铷相分布在晶粒间。

铷铁硼材料微观形貌


铷铁硼材料元素面分布结果
(2)金属间化合物(IMC)分析
CEM3000A台式扫描电镜可清晰观察到引脚焊接界面的IMC层并进行厚度测量。结合能谱,可以观察到焊料和基体的冶金结合的元素的变化趋势。

低倍下金属结合区域全貌

金属间化合物特征尺寸测量

金属间化合物元素线扫描结果
(3)粒度分布与孔隙统计
CEM3000系列台式扫描电镜通过高分辨率的成像能力,CEM3000能够精准地测量金属粉末的颗粒大小、形状及其分布情况。此外,其强大的软件定制功能能够对金属材料中的孔隙结构进行细致的统计分析,为优化材料工艺、提高产品性能提供数据支持。
金颗粒样品高倍数形貌观测

金颗粒样品颗粒识别及统计

颗粒尺寸分布图
(4)断口的失效分析
CEM3000系列台式扫描电镜能够深入到金属材料的微观结构层面,揭示裂纹的起始位置、腐蚀的扩展路径以及疲劳损伤的微观机制等。

钢丝断口样品图
图案例中,钢丝断口呈木纹状组织,放大后可见一些带状夹杂物。这些带状组织一般由铸坯而来,经轧制后演变成带状;轧制后的表面带状结构在切应力的作用下,性能下降,导致开裂。
3、选择SEM的关键决策维度
(1)首先看核心指标:
若为微纳加工领域,分辨率需≥1nm,加速电压范围50V-30kV(适配不同厚度样品);
若为食品检测(如奶粉颗粒分析),则需兼顾分辨率(≥5nm)与样品室洁净度,优先选可快速清洁的腔体设计。
(2)其次关注配套附件:
EDS能谱(成分分析)、EBSD(晶体取向分析)等附件需按需搭配,比如锂电池研究需同时观察电极形貌与元素分布,EDS是必选项;而高分子材料形貌观察,基础配置即可。
(3)最后考量售后:
SEM维护周期约6-12个月,选择本地有服务中心的品牌,可将停机时间缩短至48小时内。
访问中图仪器官网获取更多资源,或在线咨询专业技术人员解答。
568

被折叠的 条评论
为什么被折叠?



